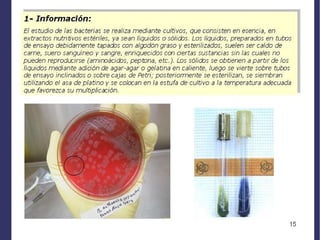

Este documento trata sobre hongos y bacterias. Explica que los hongos son organismos pertenecientes al reino Fungi con nutrición heterótrofa y pared celular de quitina. También describe las características de las bacterias como su morfología, estructura, tipos según la tinción de Gram, reproducción y mecanismos de transferencia genética. Finalmente, introduce el concepto de dominios y explica las diferencias entre Archaea, Bacteria y Eukarya.